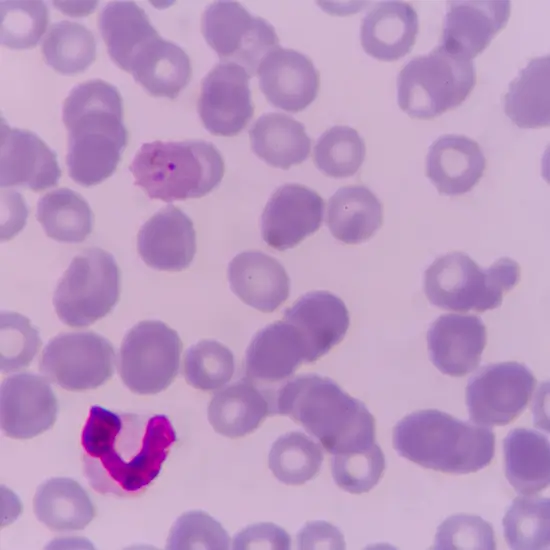

Book Malaria Parasite Appointment Online Near me at the best price in Delhi/NCR from Ganesh Diagnostic. NABL & NABH Accredited Diagnostic centre and Pathology lab in Delhi offering a wide range of Radiology & Pathology tests. Get Free Ambulance & Free Home Sample collection. 24X7 Hour Open. Call Now at 011-47-444-444 to Book your Malaria Parasite at 50% Discount.
Malaria is a contagious infectious disease that is caused by parasites of the genus Plasmodium. It is spread via the bite of an infected mosquito. P. falciparum. The malaria parasite test is a blood smear test. It is performed to determine whether malarial parasites are present in the blood or not. It helps the doctor in determining the type and quantity of malaria parasite you have in your blood.
The most common symptoms of malaria include
No particular type of care is required. Just leave your dressing strip on for at least 10 mins.
Malaria parasite blood test price in delhi
The Malaria parasite blood test price in Delhi may vary based on the location and the reputation of the diagnostic center. The average Malaria test price in Delhi is around INR 100- INR 500 . however you can book a Malaria parasite blood test at home with ganesh diagnostic center and get a discount upto 50% off.
Choose ganesh diagnostic test center for malaria parasite blood test at home
GDIC (Ganesh Diagnostic and Imaging Centre) is the best diagnostic centre for malaria parasite tests in Delhi. We provide you with the facility to get a malaria parasite test at any of our centres in Rohini, Derawal Nagar, Mangol puri, Nangloi, Hari Nagar, Budh Vihar, and Yamuna Vihar.
We provide the facility of free home sample collection to make it easy for you to get your tests done even in your busy schedule. So, if you have any queries regarding the cost of the malaria parasite test, to schedule your appointment 24*7, just give us a call to talk to our health experts.
| Test Type | Malaria Parasite |
| Includes | Malaria Parasite Test (Hematology) |
| Preparation | |
| Reporting | Within 24 hours* |
| Test Price |
₹ 100
|

Malaria is the life threatening condition which is caused by the plasmodium falciparum parasite which is transmitted to humans by the bite of infected female anopheles mosquitoes
Few symptoms of malaria are listed below :
Malaria test price in Delhi varies based on the type of test. you can book your malaria blood test in delhi with ganesh diagnostic centre and get a discount upto 50% off.
Type the malaria blood test near me in google search to check for the nearest locations available.
Avoid stagnant water, start using mosquito repellants , wear protective clothing, eat a well balanced diet, maintain hygiene and cleanliness around yourself.
The Malaria parasite blood test price in delhi varies INR 100 to INR 500 based on the location and the facility of the diagnostic centre.You can book your Malaria parasite blood test at home in Delhi at an affordable range with ganesh diagnostic center and get a discount upto 50% off
You can click on the Ganesh Diagnostic Centre website to download the Malaria parasite blood test report or get the report on a registered WhatsApp number.
Early check ups are always better than delayed ones. Safety, precaution & care is depicted from the several health checkups. Here, we present simple & comprehensive health packages for any kind of testing to ensure the early prescribed treatment to safeguard your health.